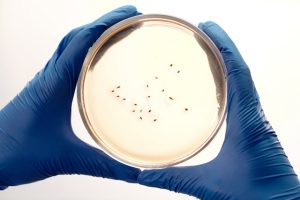
E coli Water Contamination: FAQs and Common Questions

Water microbiology focuses on microorganisms, including Water Microbiology Bacteria Viruses, that can affect drinking water quality and pose risks to human health. These microorganisms include bacteria, viruses, and parasites that can enter water systems through contamination and inadequate treatment.
Understanding microbial risks is essential for preventing waterborne diseases and ensuring safe drinking water. This guide explains the key microbiological aspects of water safety and how to manage them.
What Is Water Microbiology?
Water microbiology is the study of microorganisms present in water and their impact on water quality and human health. It examines how microbes enter water systems, how they behave, and how they can be controlled.
👉 Explore microbiology topics:
Water Microbiology
Why Water Microbiology Matters
Microbial contamination is one of the leading causes of unsafe drinking water. Unlike many chemical contaminants, microorganisms can cause immediate illness and outbreaks.
Understanding microbiology helps identify risks, improve treatment methods, and prevent disease transmission.
👉 Learn more about drinking water safety:
Drinking Water Safety
Types of Microorganisms in Water
Several types of microorganisms can be found in contaminated water:
- Bacteria (e.g., E. coli, coliform bacteria)
- Viruses (e.g., norovirus, hepatitis viruses)
- Parasites (e.g., Giardia, Cryptosporidium)
Each type of microorganism has different characteristics and health impacts.
👉 Related articles:
- Waterborne Pathogens in Drinking Water: Regulations and Standards
- Waterborne Pathogens in Drinking Water: FAQs and Common Questions
- Waterborne Pathogens in Drinking Water: Best Filters, Systems and Solutions
- Waterborne Pathogens in Drinking Water: Symptoms, Warning Signs and Red Flags
- Waterborne Pathogens in Drinking Water: Home Safety Checklist
- Waterborne Pathogens in Drinking Water: Testing and Detection Methods
- Waterborne Pathogens in Drinking Water: Removal and Treatment Options
- Waterborne Pathogens in Drinking Water: Health Effects and Risks
- Waterborne Pathogens in Drinking Water: Causes and Sources
- Waterborne Pathogens in Drinking Water: Complete Guide
- Biofilms in Water Pipes: FAQs and Common Questions
- Biofilms in Water Pipes: Best Filters, Systems and Solutions
- Biofilms in Water Pipes: Home Safety Checklist
- Biofilms in Water Pipes: Regulations and Standards
- Biofilms in Water Pipes: Removal and Treatment Options
- Biofilms in Water Pipes: Testing and Detection Methods
- Biofilms in Water Pipes: Health Effects and Risks
- Biofilms in Water Pipes: Causes and Sources
- Biofilms in Water Pipes: Complete Guide
- Biofilms in Water Pipes: Symptoms, Warning Signs and Red Flags
Health Risks of Microbial Contamination
Microbial contamination can lead to a wide range of health issues, including:
- Gastrointestinal infections
- Waterborne diseases
- Severe illness in vulnerable populations
Outbreaks can occur rapidly if contamination is not properly controlled.
👉 Learn more about contamination:
Water Contamination Guide
How Microorganisms Enter Water Systems
Microorganisms can enter water through:
- Sewage contamination
- Agricultural runoff
- Surface water infiltration
- Failures in water treatment systems
Understanding these pathways is essential for prevention.
Methods to Remove Microbial Contaminants
Several methods are effective in removing or inactivating microorganisms:
- Boiling
- UV disinfection
- Chlorination
- Filtration systems
Each method targets microbial contamination differently and may be combined for better results.
👉 Explore purification methods:
Water Purification
👉 Explore treatment systems:
Water Treatment Systems
How to Test for Microbial Contamination
Testing for microorganisms is essential because they are invisible to the naked eye.
Common methods include:
- Laboratory microbiological testing
- Indicator organisms (e.g., coliform testing)
- Rapid testing kits
👉 Full testing guide:
Water Testing
Microbial Water Safety Around the World
Microbial contamination remains a major issue in many parts of the world, particularly where sanitation and infrastructure are limited.
Improving water treatment and sanitation systems is key to reducing microbial risks globally.
👉 Explore global water quality:
Global Water Quality
Related Drinking Water Topics
Key Takeaways
- Microbial contamination is a major cause of unsafe drinking water
- Bacteria, viruses, and parasites pose different risks
- Microorganisms can enter water through multiple pathways
- Proper treatment and disinfection are essential
- Testing is required to detect microbial contamination
Final Thoughts
Water microbiology is a critical component of drinking water safety. By understanding microbial risks and how to control them, individuals and communities can reduce health risks and improve water quality.
PureWaterAtlas provides detailed resources to help you better understand microbial contamination and how to manage it effectively.
👉 Continue exploring:
Blog
👉 Explore microbiology-related articles: Water Microbiology Articles
Explore related topics
Water Microbiology
Focused content on pathogens, bacteria, viruses, and microbial risks in drinking water.
Water Contamination
Key articles covering common contaminants, exposure pathways, and health implications.
Drinking Water Safety
Practical articles to help readers understand whether their water is safe and what warning signs to watch for.